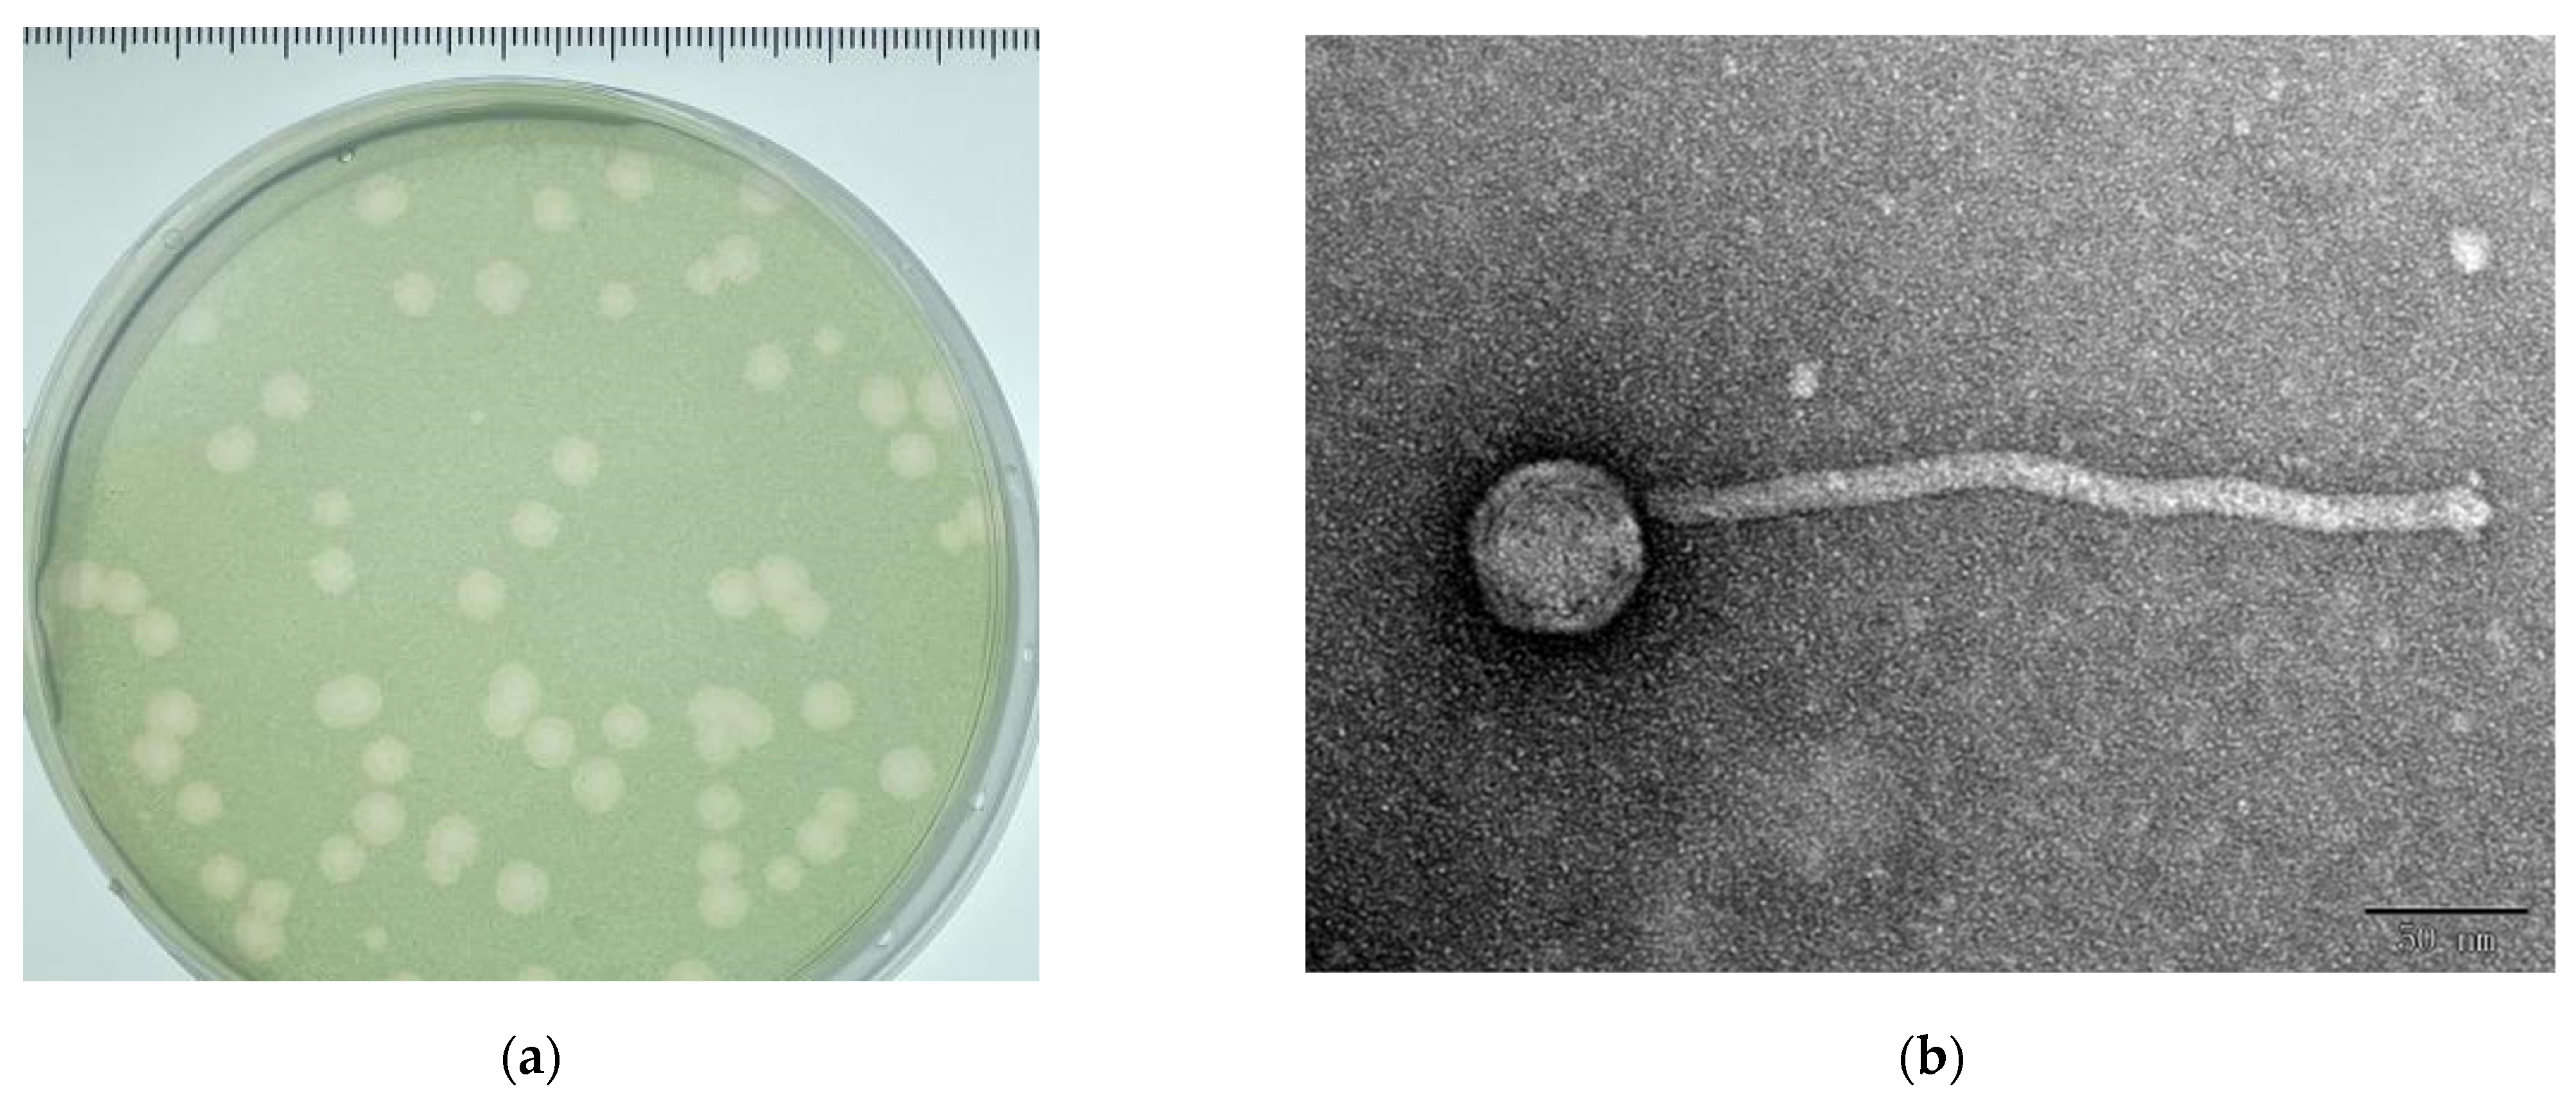
Viruses 14 00433 g001 Viruses 14 00433 g001

A Novel Wide-Range Freshwater Cyanophage MinS1 Infecting the Harmful Cyanobacterium Microcystis aeruginosa
Abstract
1. Introduction
2. Materials and Methods
2.1. Cyanophage Isolation and Purification
2.2. Transmission Electron Microscopy
2.3. Host Range
2.4. One-Step Growth Curve
2.5. Phage Stability under Environmental Stress
2.6. DNA Extraction, Sequencing and Assembly
2.7. Genome Annotation and Phylogenetic Analysis
3. Results and Discussion
3.1. Isolation and Morphology of Cyanophage MinS1
3.2. Life Cycle
3.3. Host Range
| Phage Name | Latent Period (h) | Burst Size (PFU/Cell) | Classification | Length (bp) | Accession | Host Range | Reference |
|---|---|---|---|---|---|---|---|
| 1 MaMV-DC | 24–48 | 80 | Myoviridae | 169,223 | KF356199.1 | Strain specific | [31] |
| 2 Ma-LMM01 | 6–12 | 50–120 | Myoviridae | 162,109 | AB231700.1 | Strain specific | [33] |
| 3 Ma-LBP | 11.2 | 28 | Podoviridae | - | - | - | [32] |
| 4 vB-MelS-Me-ZS1 | 108 | - | Siphoviridae | 49,665 | MK069556 | 12/15 | [5] |
| 5 phiMa05 | 24 | 127 | Myoviridae | 273,876 | MW495066.1 | Strain specific | [37] |
| 6 Mic1 | - | - | Siphoviridae | 92,627 | MN013189.1 | Strain specific | [29] |
| 7 MinS1 | 36–42 | 34 | Siphoviridae | 49,966 | MZ923504 | 19/30 | - |
3.4. Thermolability, pH, UV, Ions, Sensitivity, and Saline Stability
3.5. Genome Features
3.6. Phylogenetic Analysis
4. Conclusions
Supplementary Materials
Author Contributions
Funding
Institutional Review Board Statement
Informed Consent Statement
Data Availability Statement
Conflicts of Interest
References
- Gilbert, P.M. Eutrophication, harmful algae and biodiversity—Challenging paradigms in a world of complex nutrient changes. Mar. Pollut. Bull. 2017, 124, 591–606. [Google Scholar] [CrossRef] [PubMed]
- Hu, X.; Zhang, R.; Ye, J.; Wu, X.; Zhang, Y.; Wu, C. Monitoring and research of microcystins and environmental factors in a typical artificial freshwater aquaculture pond. Environ. Sci. Pollut. Res. 2018, 25, 5921–5933. [Google Scholar] [CrossRef] [PubMed]
- Harke, M.J.; Steffen, M.M.; Gobler, C.J.; Otten, T.G.; Wilhelm, S.W.; Wood, S.A.; Paerl, H.W. A review of the global ecology, genomics, and biogeography of the toxic cyanobacterium, Microcystis spp. Harmful Algae 2016, 54, 4–20. [Google Scholar] [CrossRef] [PubMed]
- Lin, W.; Li, D.; Sun, Z.; Tong, Y.; Yan, X.; Wang, C.; Zhang, X.; Pei, G. A novel freshwater cyanophage vB_MelS-Me-ZS1 infecting bloom-forming cyanobacterium Microcystis elabens. Mol. Biol. Rep. 2020, 47, 7979–7989. [Google Scholar] [CrossRef]
- Wu, H.; Peng, R.; Yang, Y.; He, L.; Wang, W.; Zheng, T.; Lin, G. Mariculture pond influence on mangrove areas in south China: Significantly larger nitrogen and phosphorus loadings from sediment wash-out than from tidal water exchange. Aquaculture 2014, 426, 204–212. [Google Scholar] [CrossRef]
- Plaas, H.E.; Paerl, H.W. Toxic Cyanobacteria: A Growing Threat to Water and Air Quality. Environ. Sci. Technol. 2021, 55, 44–64. [Google Scholar] [CrossRef]
- Chen, L.; Chen, J.; Zhang, X.; Xie, P. A review of reproductive toxicity of microcystins. J. Hazard. Mater. 2016, 301, 381–399. [Google Scholar] [CrossRef]
- Carmichael, W.W.; Boyer, G.L. Health impacts from cyanobacteria harmful algae blooms: Implications for the North American Great Lakes. Harm. Algae 2016, 54, 194–212. [Google Scholar] [CrossRef]
- Zhang, D.; You, F.; He, Y.; Te, S.H.; Gin, K.Y. Isolation and Characterization of the First Freshwater Cyanophage Infecting Pseudanabaena. J. Virol. 2020, 94, e00682-20. [Google Scholar] [CrossRef]
- Pentecost, A.; Whitton, B.A. The Ecology of Cyanobacteria. Their Diversity in Time and Space; Springer Science & Business Media: Berlin/Heidelberg, Germany, 2000. [Google Scholar]
- Jonge, P.A.; Nobrega, F.L.; Brouns, S.J.; Dutilh, B.E. Molecular and Evolutionary Determinants of Bacteriophage Host Range. Trends Microbiol. 2019, 27, 51–63. [Google Scholar] [CrossRef]
- Silpe, J.E.; Bassler, B.L. A Host-Produced Quorum-Sensing Autoinducer Controls a Phage Lysis-Lysogeny Decision. Cell 2019, 176, 268–280. [Google Scholar] [CrossRef]
- Suttle, C.A. Viruses in the sea. Nature 2005, 437, 356–361. [Google Scholar] [CrossRef] [PubMed]
- Xia, H.; Li, T.; Deng, F.; Hu, Z. Freshwater cyanophages. Virol. Sin. 2013, 28, 253–259. [Google Scholar] [CrossRef] [PubMed]
- Pound, H.L.; Gann, E.R.; Tang, X.; Krausfeldt, L.E.; Huff, M.; Staton, M.E.; Talmy, D.; Wilhelm, S.W. The “neglected viruses” of taihu: Abundant transcripts for viruses infecting eukaryotes and their potential role in phytoplankton succession. Front. Microbiol. 2020, 11, 338. [Google Scholar] [CrossRef] [PubMed]
- Pound, H.L.; Wilhelm, S.W. Tracing the active genetic diversity of microcystis and microcystis phage through a temporal survey of taihu. PLoS ONE 2020, 15, e0244482. [Google Scholar] [CrossRef]
- Zhang, Q.; Xing, S.; Sun, Q.; Pei, G.; Cheng, S.; Liu, Y.; An, X.; Zhang, X.; Qu, Y.; Tong, Y. Characterization and complete genome sequence analysis of a novel virulent Siphoviridae phage against Staphylococcus aureus isolated from bovine mastitis in Xinjiang, China. Virus Genes 2017, 53, 464–476. [Google Scholar] [CrossRef]
- Liu, Z.; Wang, M.; Meng, X.; Li, Y. Isolation and genome sequencing of a novel Pseudoalteromonas phage PH1. Curr. Microbiol. 2016, 74, 1–7. [Google Scholar] [CrossRef]
- Feng, T.; Leptihn, S.; Dong, K.; Loh, B. JD419, a Staphylococcus aureus Phage with a Unique Morphology and Broad Host Range. Front. Microbiol. 2021, 12, 602902. [Google Scholar] [CrossRef]
- Ding, T.; Sun, H.; Pan, Q.; Zhao, F.; Zhang, Z.; Ren, H. Isolation and characterization of Vibrio parahaemolyticus bacteriophage vB_VpaS_PG07. Virus Res. 2020, 286, 198080. [Google Scholar] [CrossRef]
- Shahin, K.; Bouzari, M. Bacteriophage application for biocontrolling Shigella flexneri in contaminated foods. J. Food Sci. Technol. 2018, 55, 550–559. [Google Scholar] [CrossRef]
- Weeks, C.R.; Ferretti, J.J. The gene for type A streptococcal exotoxin (erythrogenic toxin) is located in bacteriophage T12. Infect. Immun. 1984, 46, 531–536. [Google Scholar] [CrossRef] [PubMed]
- Bankevich, A.; Nurk, S.; Antipov, D.; Gurevich, A.A.; Dvorkin, M.; Kulikov, A.S.; Lesin, V.M.; Nikolenko, S.I.; Pham, S.; Prjibelski, A.D. SPAdes: A new genome assembly algorithm and its applications to single-cell sequencing. J. Comput. Biol. J. Comput. Mol. Cell Biol. 2012, 19, 455–477. [Google Scholar] [CrossRef] [PubMed]
- Zhang, X.; Wang, Y.; Li, S.; An, X.; Pei, G.; Huang, Y.; Fan, H.; Mi, Z.; Wei, Z.; Chen, Y.; et al. A novel termini analysis theory using HTS data alone for the identification of Enterococcus phage EF4-like genome termini. BMC Genom. 2015, 16, 1–11. [Google Scholar] [CrossRef]
- Lee, I.; Kim, Y.O.; Park, S.C.; Chun, J. OrthoANI: An improved algorithm and software for calculating average nucleotide identity. Int. J. Syst. Evol. Microbiol. 2016, 66, 1100–1103. [Google Scholar] [CrossRef]
- Nishimura, Y.; Yoshida, T.; Kuronishi, M.; Hideya, U.; Hiroyuki, O.; Susumu, G. ViPTree: The viral proteomic tree server. Bioinformatics 2017, 33, 2379–2380. [Google Scholar] [CrossRef]
- Krupovic, M.; Dutilh, B.E.; Adriaenssens, E.M.; Wittmann, J.; Vogensen, F.K.; Sullivan, M.B.; Rumnieks, J.; Prangishvili, D.; Lavigne, R.; Andrew, M. Kropinski, A.M.; et al. Taxonomy of prokaryotic viruses: Update from the ICTV bacterial and archaeal viruses subcommittee. Arch. Virol. 2016, 161, 1095–1099. [Google Scholar] [CrossRef]
- Jin, H.; Jiang, Y.L.; Yang, F.; Zhang, J.; Li, W.; Zhou, K.; Ju, J.; Chen, Y.; Zhou, C. Capsid Structure of a Freshwater Cyanophage Siphoviridae Mic1. Structure 2019, 27, 1508–1516. [Google Scholar] [CrossRef]
- Wang, D.; Jiang, Y.; Xiao, S.; Wang, M.; Liu, Q.; Huang, L.; Xue, C.; Wang, Q.; Lin, T.; Shao, H.; et al. Characterization and Genome Analysis of a Novel Alteromonas Phage JH01 Isolated from the Qingdao Coast of China. Curr. Microbiol. 2019, 76, 1256–1263. [Google Scholar] [CrossRef]
- Ou, T.; Li, S.; Liao, X.; Zhao, Q. Cultivation and characterization of the MaMV-DC cyanophage that infects bloom-forming cyanobacterium Microcystis aeruginosa. Virol. Sin. 2013, 28, 266–271. [Google Scholar] [CrossRef] [PubMed]
- Tucker, S.; Pollard, P. Identification of cyanophage Ma-LBP and infection of the cyanobacterium Microcystis aeruginosa from an Australian subtropical lake by the virus. Appl. Environ. Microbiol. 2005, 71, 629–635. [Google Scholar] [CrossRef]
- Yoshida, T.; Takashima, Y.; Tomaru, Y.; Shirai, Y.; Takao, Y.; Hiroishi, S.; Nagasaki, K. Isolation and characterization of a cyanophage infecting the toxic cyanobacterium Microcystis aeruginosa. Appl. Environ. Microbiol. 2006, 72, 1239–1247. [Google Scholar] [CrossRef]
- Xue, C.; Liu, X.; Wang, Q.; Lin, T.; Wang, M.; Liu, Q.; Shao, H.; Jiang, Y. The isolation and genome sequencing of a novel cyanophage S-H68 from the Bohai Sea, China. Mar. Genom. 2020, 53, 100739. [Google Scholar] [CrossRef]
- Parada, V.; Herndl, G.J.; Weinbauer, M.G. Viral burst size of heterotrophic prokaryotes in aquatic systems. J. Mar. Biol. Assoc. United Kingd. 2006, 86, 613–621. [Google Scholar] [CrossRef]
- Hwang, C.Y.; Cho, B.C. Virus-infected bacteria in oligotrophic open waters of the East Sea, Korea. Aquat. Microb. Ecol. 2002, 30, 1–9. [Google Scholar] [CrossRef]
- Naknaen, A.; Suttinun, O.; Surachat, K.; Khan, E.; Pomwised, R. A Novel Jumbo Phage PhiMa05 Inhibits Harmful Microcystis sp. Front. Microbiol. 2021, 12, 660351. [Google Scholar] [CrossRef] [PubMed]
- Eigemann, F.; Schwartke, M.; Schulz-Vogt, H. Niche separation of Baltic Sea cyanobacteria during bloom events by species interactions and autecological preferences. Harmful Algae 2018, 72, 65–73. [Google Scholar] [CrossRef]
- Yang, Y.; Cai, L.; Ma, R.; Xu, Y.; Tong, Y.; Huang, Y.; Jiao, N.; Zhang, R. A novel roseosiphophage isolated from the oligotrophic south china sea. Viruses 2017, 9, 109. [Google Scholar] [CrossRef]
- Zhu, P.; Zhang, B.F.; Wu, J.H.; Dang, C.Y.; Lv, Y.T.; Fan, J.Z.; Yan, X.J. Sensitive and rapid detection of microcystin synthetase E Gene (mcy E) by loop mediated isothermal amplification: A new assay for detecting the potential microcystin producing Microcystis in the aquatic ecosystem. Harmful Algae 2014, 37, 8–16. [Google Scholar] [CrossRef]
- Zhang, B.F.; Zhu, P.; Yan, X.J.; Dang, C.Y.; Lv, Y.T.; Wu, J.H. A novel assay for rapid detection of microcystin mcy G gene: Loop mediated isothermal amplification. Acta Ecol. Sinica. 2015, 35, 3104–3112. [Google Scholar]
- Li, F.; Tian, F.; Li, J.; Li, L.; Qiao, H.; Dong, Y.; Ma, F.; Zhu, S.; Tong, Y. Isolation and characterization of a podovirus infecting the opportunist pathogen Vibrio alginolyticus and Vibrio parahaemolyticus. Virus Res. 2021, 302, 198481. [Google Scholar] [CrossRef]
- Tian, F.; Li, J.; Nazir, A.; Tong, Y. Bacteriophage—A Promising Alternative Measure for Bacterial Biofilm Control. Infect. Drug Resist. 2021, 14, 205–217. [Google Scholar] [CrossRef] [PubMed]
- Chenard, C.; Chan, A.M.; Vincent, W.F.; Suttle, C.A. Polar freshwatercyanophage S-EIV1 represents a new widespread evolutionary lineage of phages. ISME J. Multidiscip. J. Microb. Ecol. 2015, 9, 2046–2058. [Google Scholar]
- Yoshida, T.; Nagasaki, K.; Takashima, Y.; Shirai, Y.; Tomaru, Y.; Takao, Y.; Sakamoto, S.; Hiroishi, S.; Ogata, H. Ma-LMM01 infecting toxic Microcystis aeruginosa illuminates diverse cyanophage genome strategies. J. Bacteriol. 2007, 190, 1762–1772. [Google Scholar] [CrossRef]
- Zhong, K.X.; Suttle, C.A.; Baudoux, A.C.; Derelle, E.; Colombet, J.; Cho, A.; Caleta, J.; Six, C.; Jacquet, S. A New Freshwater Cyanosiphovirus Harboring Integrase. Front. Microbiol. 2018, 9, 2204. [Google Scholar] [CrossRef] [PubMed]
- Ward, J.B.; Curtis, C.A.; Taylor, C.; Buxton, R.S. Purification and Characterization of Two Phage PBSX-induced Lytic Enzymes of Bacillus subtilis 168: An N-Acetylmuramoyl-l-alanine Amidase and an N-Acetylmuramidase. Microbiology 1982, 128, 1171–1178. [Google Scholar] [CrossRef] [PubMed]
- Pedulla, M.L.; Ford, M.E.; Houtz, J.M.; Karthikeyan, T.; Wadsworth, C.; Lewis, J.A.; Jacobs-Sera, D.; Falbo, J.; Gross, J.; Pannunzio, N.R.; et al. Origins of highly mosaic mycobacteriophage genomes. Cell 2003, 113, 171–182. [Google Scholar] [CrossRef]
- Gao, E.B.; Gui, J.F.; Zhang, Q.Y. A novel cyanophage with a cyanobacterial nonbleaching protein A gene in the genome. J. Virol. 2012, 86, 236–245. [Google Scholar] [CrossRef] [PubMed]
- Neuwald, A.F.; Aravind, L.; Spouge, J.L.; Koonin, E.V. AAA+: A Class of Chaperone-Like ATPases Associated with the Assembly, Operation, and Disassembly of Protein Complexes. Genome Res. 1999, 9, 27–43. [Google Scholar] [CrossRef] [PubMed]
- Dion, M.B.; Oechslin, F.; Moineau, S. Phage diversity, genomics and phylogeny. Nat. Rev. Microbiol. 2020, 18, 125–138. [Google Scholar] [CrossRef]
- Zhang, L.; Huang, Y.; Xu, D.; Yang, L.; Qian, K.; Chang, G.; Gong, Y.; Zhou, X.; Ma, K. Biochemical characterization of a thermostable HNH endonuclease from deep-sea thermophilic bacteriophage GVE2. Appl. Microbiol. Biotechnol. 2016, 100, 8003–8012. [Google Scholar] [CrossRef]
- Ivanov, R.; Tiedemann, J.; Czihal, A.; Schallau, A.; Diep, L.H.; Mock, H.; Claus, B.; Tewes, A.; Bäumlein, H. EFFECTOR OF TRANSCRIPTION2 is involved in xylem differentiation and includes a functional DNA single strand cutting domain. Dev. Biol. 2008, 313, 93–106. [Google Scholar] [CrossRef] [PubMed][Green Version]
- Roey, P.V.; Meehan, L.; Kowalski, J.C.; Belfort, M.; Derbyshire, V. Catalytic domain structure and hypothesis for function of GIY-YIG intron endonuclease I-TevI. Nat. Struct. Biol. 2002, 9, 806–811. [Google Scholar] [PubMed]
- Touchon, M.; Moura, D.; Rocha, E.P. Embracing the enemy: The diversification of microbial gene repertoires by phage-mediated horizontal gene transfer. Curr. Opin. Microbiol. 2017, 38, 66–73. [Google Scholar] [CrossRef] [PubMed]
- Dlakić, M. Functionally unrelated signalling proteins contain a fold similar to Mg2+-dependent endonucleases. Trends Biochem. Sci. 2000, 25, 272–273. [Google Scholar] [CrossRef]

| Orders | Family | Species | Strains | Susceptibility | Toxin | Origin |
|---|---|---|---|---|---|---|
| Chroococcales | Microcystaceae | Microcystis aeruginosa | FACHB-905 | + | * | China |
| FACHB-942 | − | * | China | |||
| FACHB-469 | + | France | ||||
| FACHB-924 | − | * | Australia | |||
| FACHB-1326 | + | China | ||||
| M. wesenbergii | FACHB-908 | + | China | |||
| FACHB-1112 | − | China | ||||
| FACHB-1317 | + | China | ||||
| FACHB-1318 | + | China | ||||
| FACHB-929 | + | * | Japan | |||
| M. viridis | FACHB-979 | − | * | Japan | ||
| FACHB-1342 | + | China | ||||
| FACHB-1337 | + | China | ||||
| M. Flos-aquae | FACHB-1028 | − | * | China | ||
| FACHB-1323 | − | China | ||||
| Microcystis sp. | FACHB-915 | + | * | France | ||
| M. elabens | FACHB-916 | − | Japan | |||
| Chroococcacaea | Chroococcus sp. | FACHB-193 | − | China | ||
| Nostocales | Aphanizomenonaceae | Aphanizomenon flos-aquae | FACHB-1040 | − | China | |
| Anabaena flos-aquae | FACHB-245 | + | America | |||
| Dolichospermum flos-aquae | FACHB-1255 | + | China | |||
| Nostocaceae | Nostoc sp. | FACHB-596 | + | * | China | |
| Oscillatoriales | Microcoleaceae | Planktothrix agardhii | FACHB-1166 | + | China | |
| Planktothricoides raciborskii | FACHB-881 | + | China | |||
| Oscillatoriaceae | Oscillatoria planctonica | FACHB-708 | + | China | ||
| Hormogonales | Scytonemataceae | Plectonema | FACHB-402 | + | America | |
| FACHB-240 | − | America | ||||
| Synechococcales | Synechococcaceae | Synechococcus sp. | FACHB-805 | + | Australia | |
| FACHB-1061 | + | China |
| ORF | Size (aa) | Strand | Prediction Function | Top BLAST Hit a | Identity b (aa) | Query Cover | E-Value c |
|---|---|---|---|---|---|---|---|
| 1 | 24 | _ | hypothetical protein | WP_193613138.1|Hypothetical protein [Nocardioides lijunqiniae] | 18/27 (67%) | 100% | 4 × 10−5 |
| 2 | 75 | _ | hypothetical protein | YP_009950949.1|Hypothetical protein I5G75_gp45 [Mycobacterium phage Rando14] | 26/59 (44%) | 77% | 6 × 10−4 |
| 3 | 64 | _ | No hit | No hit | |||
| 4 | 563 | _ | AAA family ATPase | WP_085894220.1|AAA family ATPase [Nocardioides sp. PD653] | 384/552 (70%) | 97% | 0 |
| 5 | 196 | _ | hypothetical protein | WP_038679418.1|hypothetical protein [Pimelobacter simplex] | 61/157 (39%) | 77% | 8 × 10−24 |
| 6 | 100 | _ | hypothetical protein | WP_085894217.1|hypothetical protein [Nocardioides sp. PD653] | 59/100 (59%) | 100% | 7 × 10−28 |
| 7 | 403 | _ | Lsr2 family protein | WP_181312490.1|Lsr2 family protein [Nocardioides sp. Y192] | 213/385 (55%) | 94% | 2 × 10−135 |
| 8 | 59 | _ | hypothetical protein | WP_091115340.1|hypothetical protein [Nocardioides psychrotolerans] | 22/53 (42%) | 89% | 0.016 |
| 9 | 160 | _ | RusA family crossover junction endodeoxyribonuclease | WP_160006778.1|RusA family crossover junction endodeoxyribonuclease [Nocardioides sp. AX2bis] | 106/157 (68%) | 98% | 9 × 10−70 |
| 10 | 107 | _ | hypothetical protein | WP_135361668.1|hypothetical protein [Mycolicibacterium peregrinum] | 56/86 (65%) | 80% | 7 × 10−29 |
| 11 | 93 | _ | No hit | No hit | |||
| 12 | 97 | _ | No hit | No hit | |||
| 13 | 94 | _ | No hit | No hit | |||
| 14 | 225 | _ | hypothetical protein | WP_068120810.1|hypothetical protein [Nocardioides massiliensis] | 144/225 (64%) | 99% | 1 × 10−89 |
| 15 | 72 | _ | No hit | No hit | |||
| 16 | 270 | _ | MULTISPECIES: 3′-5′ exonuclease | WP_165763480.1|MULTISPECIES: 3′-5′ exonuclease [unclassified Nocardioides] | 140/271 (52%) | 100% | 6 × 10−91 |
| 17 | 118 | _ | gp121 | NP_818419.1|gp121 [Mycobacterium virus Omega] | 62/113 (55%) | 95% | 1 × 10−33 |
| 18 | 396 | _ | hypothetical protein | WP_160006801.1|hypothetical protein [Nocardioides sp. AX2bis] | 260/403 (65%) | 99% | 2 × 10−156 |
| 19 | 95 | _ | Kinase domain protein | XP_001019386.2|kinase domain protein [Tetrahymena thermophila SB210] | 26/84 (31%) | 76% | 0.003 |
| 20 | 313 | _ | hypothetical protein | WP_160006807.1|hypothetical protein [Nocardioides sp. AX2bis] | 270/313 (86%) | 100% | 0.0 |
| 21 | 78 | _ | No hit | No hit | |||
| 22 | 132 | _ | hypothetical protein | NGZ99671.1|hypothetical protein [Nocardioides convexus] | 53/131 (40%) | 86% | 7 × 10−10 |
| 23 | 115 | _ | No hit | No hit | |||
| 24 | 70 | _ | helix-turn-helix domain-containing protein | WP_091115310.1|helix-turn-helix domain-containing protein [Nocardioides psychrotolerans] | 39/62 (63%) | 88% | 3 × 10−22 |
| 25 | 98 | _ | helix-turn-helix domain-containing protein | WP_191563416.1|helix-turn-helix domain-containing protein [Janibacter melonis] | 52/91 (57%) | 91% | 6 × 10−28 |
| 26 | 144 | + | hypothetical protein | WP_166844276.1|hypothetical protein [Pseudoteredinibacter isoporae] | 65/131 (50%) | 88% | 2 × 10−30 |
| 27 | 139 | + | hypothetical protein | WP_157346146.1|MULTISPECIES: hypothetical protein [unclassified Nocardioides] | 76/132 (58%) | 94% | 2 × 10−46 |
| 28 | 107 | + | hypothetical protein | WP_109746752.1|hypothetical protein [Salinispora mooreana] | 44/73 (60%) | 68% | 3 × 10−22 |
| 29 | 393 | + | site-specific integrase | GEP38839.1|site-specific integrase [Nocardioides psychrotolerans] | 224/374 (60%) | 94% | 6 × 10−130 |
| 30 | 96 | _ | DUF3263 domain-containing protein | WP_020105292.1|DUF3263 domain-containing protein [Nocardia sp. 348MFTsu5.1] | 42/73 (58%) | 76% | 2 × 10−18 |
| 31 | 314 | _ | tyrosine-type recombinase/integrase | NUO57292.1|tyrosine-type recombinase/integrase [Hamadaea sp.] | 137/311 (44%) | 98% | 1 × 10−74 |
| 32 | 96 | _ | hypothetical protein | WP_182541196.1|hypothetical protein [Nocardioides ginsengisegetis] | 48/93 (52%) | 96% | 3 × 10−16 |
| 33 | 51 | _ | hypothetical protein | WP_183407729.1|hypothetical protein [Marmoricola ginsengisoli] | 26/50 (52%) | 98% | 5 × 10−8 |
| 34 | 167 | _ | helix-turn-helix domain-containing protein | WP_157537489.1|helix-turn-helix domain-containing protein [Nocardioides sp. Root190] | 66/144 (46%) | 81% | 5 × 10−25 |
| 35 | 48 | _ | No hit | No hit | |||
| 36 | 130 | _ | hypothetical protein | WP_013861876.1|hypothetical protein [Microlunatus phosphovorus] | 42/82 (51%) | 63% | 3 × 10−17 |
| 37 | 301 | _ | endonuclease/exonuclease/phosphatase family protein | MBA3989807.1|endonuclease/exonuclease/phosphatase family protein [Propionibacteriales bacterium] | 69/249 (28%) | 94% | 1 × 10−5 |
| 38 | 278 | _ | N-acetylmuramoyl-L-alanine amidase | WP_067428568.1|N-acetylmuramoyl-L-alanine amidase [Nocardioides jensenii] | 117/211 (55%) | 75% | 1 × 10−64 |
| 39 | 231 | _ | collagen-like protein | WP_091115432.1|collagen-like protein [Nocardioides psychrotolerans] | 100/230 (43%) | 95% | 9 × 10−27 |
| 40 | 55 | _ | hypothetical protein | WP_170259192.1|hypothetical protein [Nocardioides psychrotolerans] | 30/55 (55%) | 100% | 1 × 10−12 |
| 41 | 104 | _ | hypothetical protein | WP_143099800.1|hypothetical protein [Nocardioides psychrotolerans] | 48/83 (58%) | 79% | 6 × 10−25 |
| 42 | 800 | _ | hypothetical protein | WP_179792624.1|hypothetical protein [Actinomycetospora corticicola] | 133/421 (32%) | 48% | 7 × 10−31 |
| 43 | 148 | _ | hypothetical protein | WP_193613168.1|hypothetical protein [Nocardioides lijunqiniae] | 37/95 (39%) | 63% | 1 × 10−10 |
| 44 | 548 | _ | hypothetical protein | WP_193613167.1|hypothetical protein [Nocardioides lijunqiniae] | 276/548 (50%) | 99% | 4 × 10−168 |
| 45 | 491 | _ | hypothetical protein | WP_193613166.1|hypothetical protein [Nocardioides lijunqiniae] | 175/492 (36%) | 98% | 3 × 10−73 |
| 46 | 1155 | _ | phage tail tape measure protein | WP_091115412.1|phage tail tape measure protein [Nocardioides psychrotolerans] | 396/777 (51%) | 64% | 0.0 |
| 47 | 130 | _ | hypothetical protein | WP_091115411.1|hypothetical protein [Nocardioides psychrotolerans] | 73/129 (57%) | 96% | 2 × 10−38 |
| 48 | 232 | _ | hypothetical protein | WP_091115408.1|hypothetical protein [Nocardioides psychrotolerans] | 103/228 (45%) | 97% | 1 × 10−57 |
| 49 | 39 | _ | No hit | No hit | |||
| 50 | 173 | _ | hypothetical protein | WP_085894250.1|hypothetical protein [Nocardioides sp. PD653] | 109/169 (64%) | 97% | 2 × 10−72 |
| 51 | 75 | _ | hypothetical protein | WP_085894249.1|hypothetical protein [Nocardioides sp. PD653] | 52/76 (68%) | 100% | 6 × 10−26 |
| 52 | 179 | _ | hypothetical protein | WP_085894248.1|ypothetical protein [Nocardioides sp. PD653] | 87/178 (49%) | 79% | 2 × 10−40 |
| 53 | 121 | _ | HK97 gp10 family phage protein | WP_068125082.1|HK97 gp10 family phage protein [Nocardioides massiliensis] | 80/121 (66%) | 100% | 5 × 10−50 |
| 54 | 151 | _ | DUF6093 family protein | WP_091115395.1|DUF6093 family protein [Nocardioides psychrotolerans] | 77/153 (50%) | 98% | 5 × 10−29 |
| 55 | 124 | _ | hypothetical protein | WP_091115392.1|hypothetical protein [Nocardioides psychrotolerans] | 82/121 (68%) | 95% | 6 × 10−47 |
| 56 | 114 | _ | hypothetical protein | WP_193613156.1|hypothetical protein [Nocardioides lijunqiniae] | 66/113 (58%) | 98% | 5 × 10−25 |
| 57 | 376 | _ | hypothetical protein | WP_193613155.1|hypothetical protein [Nocardioides lijunqiniae] | 311/374 (83%) | 99% | 0.0. |
| 58 | 133 | _ | DUF2190 family protein | WP_193613154.1|DUF2190 family protein [Nocardioides lijunqiniae] | 111/136 (82%) | 100% | 2 × 10−64 |
| 59 | 430 | _ | hypothetical protein | WP_220138645.1|hypothetical protein [Nocardioides massiliensis] | 210/352 (60%) | 81% | 4 × 10−127 |
| 60 | 63 | _ | No hit | No hit | |||
| 61 | 57 | + | hypothetical protein | NUR90848.1|hypothetical protein [Nonomuraea sp.] | 40/55 (73%) | 94% | 5 × 10−15 |
| 62 | 186 | _ | HNH endonuclease | WP_114027590.1|HNH endonuclease [Sphaerisporangium album] | 89/179 (50%) | 97% | 6 × 10−43 |
| 63 | 353 | _ | hypothetical protein | WP_091115383.1|hypothetical protein [Nocardioides psychrotolerans] | 224/350 (64%) | 99% | 1 × 10−154 |
| 64 | 525 | _ | hypothetical protein | WP_193613151.1|hypothetical protein [Nocardioides lijunqiniae] | 393/528 (74%) | 99% | 0.0 |
| 65 | 508 | _ | phage terminase large subunit | WP_210651751.1|phage terminase large subunit [Nocardioides sp. SYSU D00065] | 382/516 (74%) | 98% | 0.0 |
| 66 | 179 | _ | GIY-YIG nuclease family protein | WP_131823145.1|GIY-YIG nuclease family protein [Mycolicibacterium sp. (ex Dasyatis americana)] | 58/167 (35%) | 93% | 7 × 10−18 |
| 67 | 485 | _ | hypothetical protein | WP_193613147.1|hypothetical protein [Nocardioides lijunqiniae] | 265/473 (56%) | 97% | 1 × 10−166 |
| 68 | 77 | _ | hypothetical protein | WP_183591126.1|hypothetical protein [Nocardioides soli] | 37/84 (44%) | 100% | 1 × 10−6 |
| 69 | 88 | _ | No hit | No hit | |||
| 70 | 63 | _ | No hit | No hit | |||
| 71 | 125 | _ | DUF4326 domain-containing protein | WP_191008157.1|DUF4326 domain-containing protein [Microbacterium hominis] | 55/117 (47%) | 93% | 3 × 10−26 |
| 72 | 115 | _ | hypothetical protein | WP_091115362.1|hypothetical protein [Nocardioides psychrotolerans] | 63/86 (73%) | 74% | 6 × 10−36 |
| 73 | 99 | _ | hypothetical protein | WP_085894225.1|hypothetical protein [Nocardioides sp. PD653] | 84/93 (90%) | 93% | 4 × 10−55 |
| 74 | 51 | _ | No hit | No hit | |||
| 75 | 199 | _ | hypothetical protein | WP_068121038.1|hypothetical protein [Nocardioides massiliensis] | 139/202 (69%) | 100% | 4 × 10−87 |
Publisher’s Note: MDPI stays neutral with regard to jurisdictional claims in published maps and institutional affiliations. |
© 2022 by the authors. Licensee MDPI, Basel, Switzerland. This article is an open access article distributed under the terms and conditions of the Creative Commons Attribution (CC BY) license (https://creativecommons.org/licenses/by/4.0/).
Share and Cite
Zhang, S.; He, X.; Cao, L.; Tong, Y.; Zhao, B.; An, W. A Novel Wide-Range Freshwater Cyanophage MinS1 Infecting the Harmful Cyanobacterium Microcystis aeruginosa. Viruses 2022, 14, 433. https://doi.org/10.3390/v14020433
Zhang S, He X, Cao L, Tong Y, Zhao B, An W. A Novel Wide-Range Freshwater Cyanophage MinS1 Infecting the Harmful Cyanobacterium Microcystis aeruginosa. Viruses. 2022; 14(2):433. https://doi.org/10.3390/v14020433
Chicago/Turabian StyleZhang, Shanshan, Xiaoqi He, Lei Cao, Yigang Tong, Baohua Zhao, and Wenlin An. 2022. "A Novel Wide-Range Freshwater Cyanophage MinS1 Infecting the Harmful Cyanobacterium Microcystis aeruginosa" Viruses 14, no. 2: 433. https://doi.org/10.3390/v14020433
APA StyleZhang, S., He, X., Cao, L., Tong, Y., Zhao, B., & An, W. (2022). A Novel Wide-Range Freshwater Cyanophage MinS1 Infecting the Harmful Cyanobacterium Microcystis aeruginosa. Viruses, 14(2), 433. https://doi.org/10.3390/v14020433
